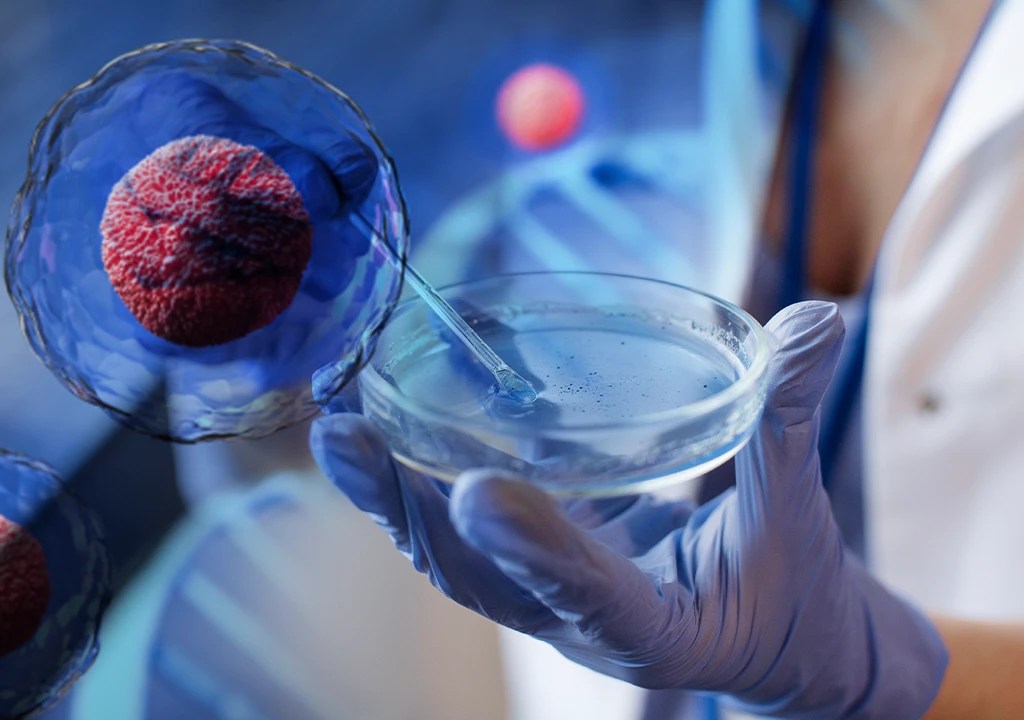

Las células madre mesenquimales se han convertido en una de las terapias más prometedoras para tratar la degeneración articular. Son capaces de transformarse en aquellos tejidos que necesitas, ayudando a reparar y regenerar las células dañados.
Un nuevo comienzo
A diferencia de los tratamientos convencionales que solo alivian el dolor, las células madre estimulan la producción natural de colágeno y cartílago, mejoran la lubricación articular y reducen la inflamación crónica. El resultado es una articulación más fuerte, flexible y funcional.
Movilidad sin cirugía
Esta terapia avanzada que te traen nuestros médicos cubanos, permite evitar o retrasar procedimientos quirúrgicos, ya que promueve la restauración natural del tejido sin necesidad de prótesis ni largos periodos de recuperación. Muchos pacientes experimentan alivio del dolor y mayor movilidad en pocas semanas.
A tu alcance
Realizando el procedimiento con las células madre mesenquimales, tienes una oportunidad para recuperar la calidad de vida, moverte sin dolor y envejecer con articulaciones activas y saludables. Para conocer más, agenda una cita al teléfono: 944 861 608






Deja un comentario